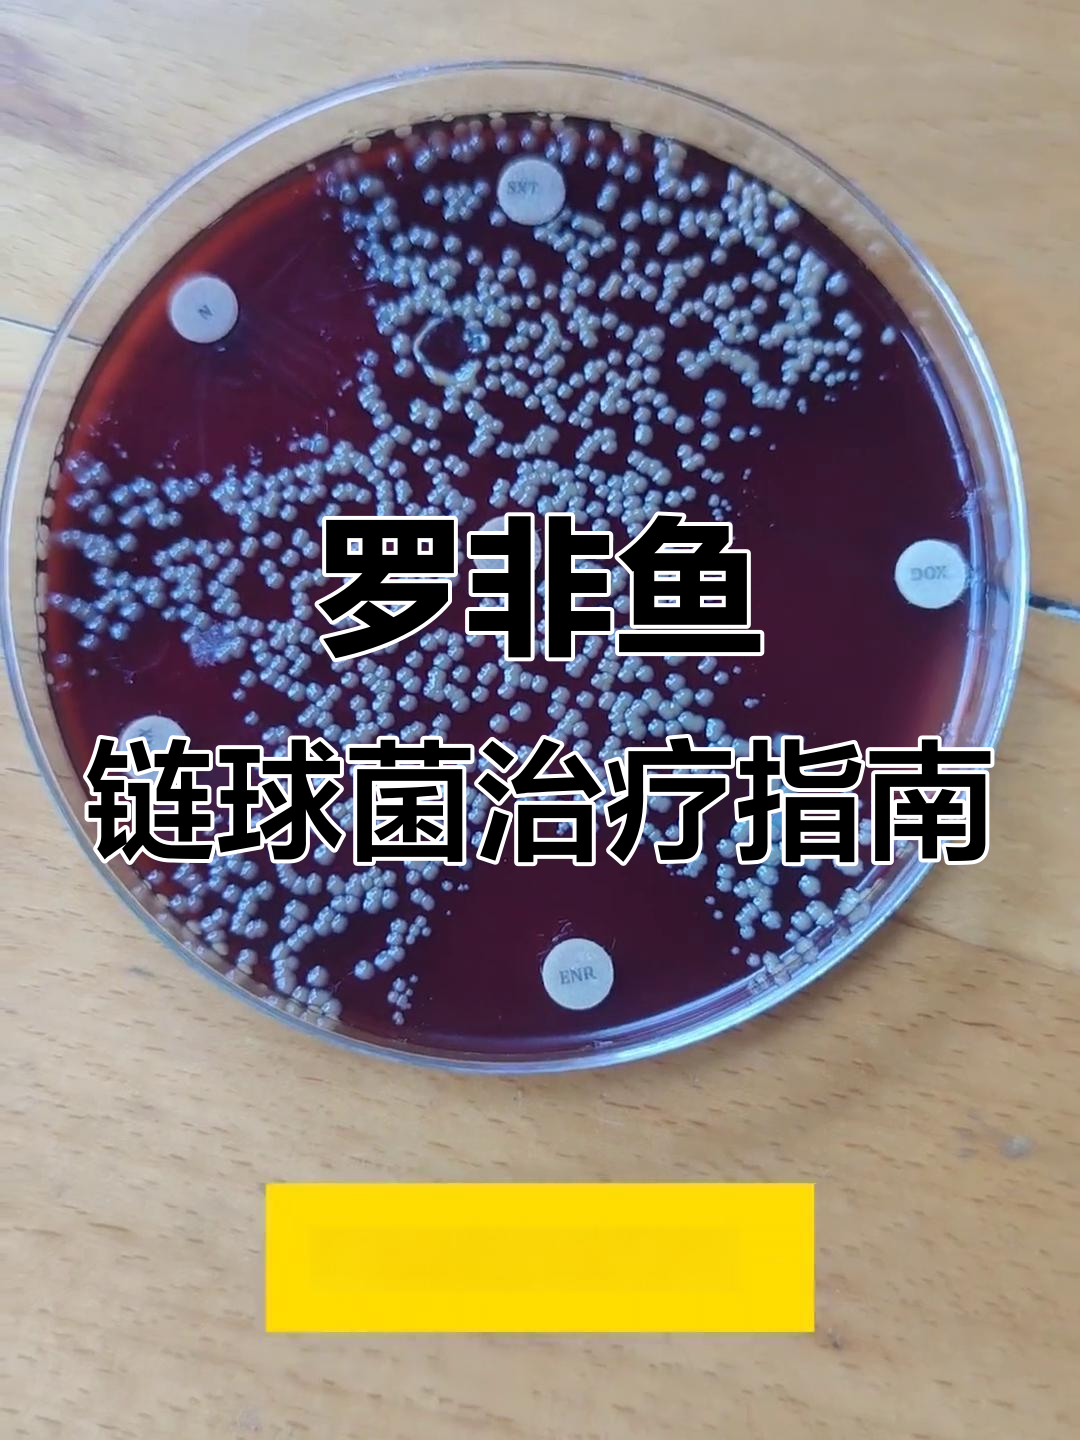
罗非鱼链球菌耐药性分析:最敏感药物与治疗方案

罗非鱼感染链球菌的治疗方法相关视频
罗非鱼链球菌最佳治疗方法
给罗非鱼刺伤手会感染无乳链球菌
罗非鱼烂身病治疗方法
罗非鱼烂鳃病治疗方法
罗非鱼链球菌治疗方法
罗非鱼常见病治疗方法
罗非鱼肝胆综合症治疗方法
罗非鱼凸眼的治疗方法
罗非鱼感染链球菌的治疗方法
罗非鱼肠炎病治疗方法
罗非鱼套肠病治疗方法
罗非鱼感染链球菌的治疗方法视频列表
-
01:31
罗非鱼养殖中链球菌病高发:水温过高 用户:山野农小哥 -
00:32
农村池塘罗非鱼链球菌病防控,控温 + 益生菌调水 用户:得梦在2c -
01:16
罗非鱼链球菌耐药性分析:最敏感药物与治疗方案 用户:游戏汇
01:16
罗非鱼链球菌耐药性分析:最敏感药物与治疗方案 用户:游戏汇 -
 00:11
鱼链球菌感染怎么办?了解应对方法 用户:福运临林
00:11
鱼链球菌感染怎么办?了解应对方法 用户:福运临林 -
 00:10
近期高发链球菌问题,罗非鱼养殖如何应对? 用户:柴柴金宝库
00:10
近期高发链球菌问题,罗非鱼养殖如何应对? 用户:柴柴金宝库 -
01:26
罗非鱼链球菌病:水温过高引发爆发 用户:田畔新农人 -
01:46
罗非鱼腹部发红是什么原因 用户:图槐帐伊娜吨 -
 00:56
一分钟了解无乳链球菌 用户:秒懂百科
00:56
一分钟了解无乳链球菌 用户:秒懂百科 -
02:14
鱼链球菌病特效药 用户:农业引路人 -
 00:19
夏季高温警惕罗非鱼链球菌,益如联康守护水产健康 用户:追剧上头实录
00:19
夏季高温警惕罗非鱼链球菌,益如联康守护水产健康 用户:追剧上头实录